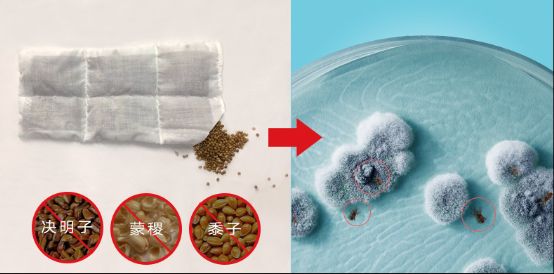

Evebaby凝胶手臂枕的开创者
随着社会经济和科技的发展,各行各业的实用黑科技产品越来越丰富,品牌商们也都绞尽脑汁,都在努力做产品研发和创新。

在母婴品牌近期冉冉升起的一颗新星,就是中泰联合品牌——Evebaby,其研发创造的第五代凝胶手臂枕获得了市场非常热切的追捧和好评。在Evebaby提出凝胶手臂枕概念前,市面上只有植物颗粒的哺乳手臂枕,其产品作用只是相对隔热隔汗,使得妈妈的手臂得到一定的舒缓作用,而没有真的有夏日凉爽的感觉。而且由于每天的哺乳时间长、次数多,宝宝在吃奶的时候分泌的汗液不断的渗透到植物枕芯,如果没有及时清洗和晾晒,非常容易滋生细菌,甚至霉变长虫。
在了解到这款产品的种种问题后,Evebaby的产品总监Arabella亲自带领公司的研发团队,经过一年多的不断优化改良,从硅胶、纯水水袋到最终使用类退热贴材质的医用级凝胶作为手臂枕枕芯,并且给数百位哺乳期妈妈进行安全使用测试,且在数十个原创设计的枕套中挑出了最受妈妈们喜爱的几款于2019年2月推向市场,一上市就广受用户的好评和热切的购买。

Evebaby一直致力于创造安全、优质的母婴产品,且在现有的产品上不断的优化升级,只合作国内最优质的面料及其他辅助产品供应商,不生产售卖任何低价劣质的产品,优中选优,聆听妈妈们在抚育宝宝中的痛点难点,不断的升级优化自己的产品,给妈妈和宝宝提供更多实用、安全和高颜值的产品。

中国的知识产权保护还在不断的完善中,目前市面上已经开始有人跃跃欲试想要抄袭或者模仿Evebaby创新研发的凝胶手臂枕,但是Evebaby作为凝胶手臂枕的开创者,不会停步不前,会不断的优化和改进产品,让妈妈和宝宝们能用到更舒适安全的优质产品。
网址:Evebaby凝胶手臂枕的开创者 https://c.jiaju82.com/news-view-id-644001.html